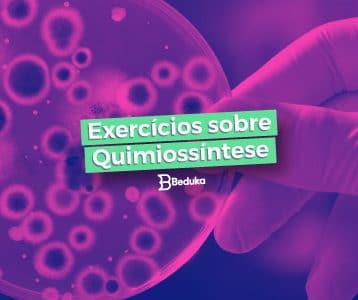

A Fisiologia Vegetal é uma área da botânica que estuda o funcionamento das funções moleculares, mecânicas...
O Plano Cartesiano é uma ferramenta matemática gráfica, ou seja, desenhada com duas dimensões. Ele é...
A quimiossíntese é um processo autotrófico que produz energia orgânica por meio da matéria inorgânica, sem...
Energia térmica é um tipo de energia associada à temperatura absoluta do sistema, dada pela soma...
A transformação da matéria é o objeto de estudo da Química, então os químicos precisam usar...
Fisiologia vegetal é área da biologia botânica que estuda as funções internas das plantas. Nela, analisamos...
Visão espacial matemática é a habilidade de identificar, situar e posicionar corpos no local. Ela é...
Hereditariedade é o fenômeno biológico de transmissão das características, feita de pais para filhos. Isso só...
Energia térmica é um tipo de energia associada à temperatura absoluta do sistema, dada pela soma...
As grandezas químicas são agrupamentos de categorias (átomos, elementos, mol, …) para termos referência na hora...
Descubra o que é Quimiossíntese, quem a realiza, qual sua importância, como ela ocorre e quais
As Leis Ponderais são afirmações sobre o comportamento das massas em experimentos com reações químicas. Lavoisier,...